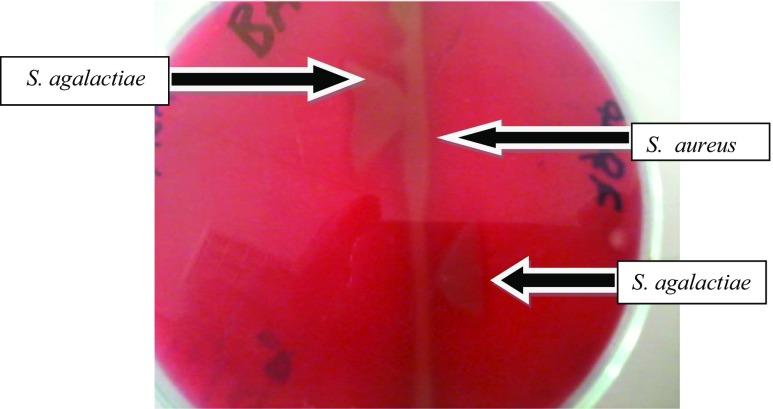
https://cdn.ncbi.nlm.nih.gov/pmc/blobs/1686/6597589/911c53272265/11250_2019_1838_Fig1_HTML.jpg

埃塞俄比亚东部哈勒马亚区及其周边农场牛乳腺炎的危险因素以及无乳链球菌的分离与鉴定
Risk factors for bovine mastitis with the isolation and identification of Streptococcus agalactiae from farms in and around Haramaya district, eastern Ethiopia.
作者信息
Lakew Biniam Tsegaye, Fayera Taresa, Ali Yimer Muktar
机构信息
College of Veterinary Medicine, Haramaya University, P.O.Box 138, Dire Dawa, Ethiopia.
School of Environmental and Rural Science, University of New England, Armidale, 2351, Australia.
出版信息
Trop Anim Health Prod. 2019 Jul;51(6):1507-1513. doi: 10.1007/s11250-019-01838-w. Epub 2019 Feb 11.
A cross-sectional study was carried out to determine the prevalence and risk factors of bovine mastitis caused by Streptococcus agalactiae from farms in and around Haramaya district, eastern Ethiopia. A total of 384 lactating cows were selected from small-, medium-, and large-scale production systems. California mastitis test (CMT) was used for screening subclinical mastitis. Out of the total animals examined, 63.02% (n = 242) had mastitis, where 6.77% (n = 26) and 56.25% (n = 216) were clinical and subclinical mastitis respectively. The quarter-level prevalence was 29.04% (n = 446), from which the clinical form was 6.38% (n = 98) and the subclinical was 22.66% (n = 348), and the rest quarters were blind 3.32% (n = 51). Milk samples from clinical as well as CMT positive quarters were cultured for isolation of S. agalactiae, where 10.3% (n = 46) resulted in growth of the bacterium. The prevalence of mastitis was found to be statistically significant among the age groups (p = 0.002), breed (p = 0.000), and parity (p = 0.000). Similar findings were found to the extrinsic risk factors considered; as production type (p = 0.010), teat injury (p = 0.02), and type of floor (p = 0.000). The study confirmed the importance of S. agalactiae as the cause of contagious mastitis and also identified the associated risk factors in the study farms and hence warrants serious attention.
开展了一项横断面研究,以确定埃塞俄比亚东部哈拉马亚区及其周边农场无乳链球菌引起的牛乳腺炎的患病率和风险因素。从小型、中型和大型生产系统中总共选取了384头泌乳奶牛。采用加利福尼亚乳房炎检测法(CMT)筛查亚临床乳腺炎。在检查的所有动物中,63.02%(n = 242)患有乳腺炎,其中临床乳腺炎和亚临床乳腺炎分别占6.77%(n = 26)和56.25%(n = 216)。乳房四分位患病率为29.04%(n = 446),其中临床型为6.38%(n = 98),亚临床型为22.66%(n = 348),其余四分位为隐性3.32%(n = 51)。对临床以及CMT检测呈阳性的乳房四分位的牛奶样本进行培养,以分离无乳链球菌,其中10.3%(n = 46)培养出该细菌。乳腺炎患病率在年龄组(p = 0.002)、品种(p = 0.000)和胎次(p = 0.000)之间存在统计学显著差异。在所考虑的外部风险因素中也发现了类似结果;如生产类型(p = 0.010)、乳头损伤(p = 0.02)和畜舍地面类型(p = 0.000)。该研究证实了无乳链球菌作为传染性乳腺炎病因的重要性,并确定了研究农场中的相关风险因素,因此值得高度关注。